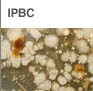

|
 |
| |
 |
¢Â CMIT MIT
¢Â¿ë µµ: Á¦Áö¿ë Slime controlÁ¦,¶óÅØ½º,ÀüºÐÈ£·á,¼¶À¯À¯Á¦,Cosmetics,¸ñÀç, Paint,ÈÀåǰµî À§»ýǰ¿ë,±Ý¼Ó Àý»èÀ¯,°øÁ¤¼öµîÀÇ Á¦Ç° ºÎÆÐ ¹× º¯Áú¹æÁö ¢ÂÀå Á¡ ¡á¼ÓÈ¿¼ºÀÌ ¿ì¼öÇϰí, ±¤¹üÀ§ÇÑ Á¾·ùÀÇ ¹Ì»ý¹°¿¡ È¿°úÀûÀÔ´Ï´Ù. ¡áÀú³óµµ¿¡¼µµ ¿ì¼öÇÑ È°¼ºÀ» º¸À̸ç, ¾àÈ¿°¡ Àå±â°£ Áö¼ÓµË´Ï´Ù. ¡áBiofilmÀ» Á¦°ÅÇϰí À缺ÀåÀ» ¾ïÁ¦ÇÕ´Ï´Ù. ¡á¹°¿¡ ¿ÏÀüÈ÷ ¿ëÇØµÇ¸ç, ¿©·¯°¡Áö Solvent¿Í È¥¿ë¼ºÀÌ ¿ì¼öÇÕ´Ï´Ù. ¡á»ýºÐÇØ¼ºÀÌ ¿ì¼öÇÏ¿© ȯ°æ¹®Á¦¸¦ ÀÏÀ¸Å°Áö ¾Ê½À´Ï´Ù. ¡á°ÅǰÀÌ »ý±âÁö ¾ÊÀ¸¸ç, Formaldehyde°¡ ¹ß»ýÇÏÁö ¾Ê½À´Ï´Ù. ¡á³¿»õ°¡ ¾øÀ¸¸ç, »ç¿ëÈÄ »ö±ò¿¡ º¯È¸¦ ÁÖÁö ¾Ê½À´Ï´Ù. ¡áÁ¶·ù¿¡ ´ëÇÑ È¿°ú°¡ ¸Å¿ì Ź¿ùÇÕ´Ï´Ù.
|
| ¢Â DBNPA
¢Â¿Ü°ü: ¹«»ö ¶Ç´Â Ȳ°¥»öÀÇ Åõ¸íÇÑ ¾×ü ¢Â³¿»õ: ºÎµå·¯¿î Çâ±â°¡ ÀÖÀ½ ¢ÂPH : 3.0¡¾1.0 ¢ÂºñÁß: 20¡É¿¡¼ ¾à1.20 ¢Â²ú´ÂÁ¡/²ú´ÂÁ¡ ¹üÀ§: ÀÚ·á¾øÀ½ ¢Â³ì´ÂÁ¡/³ì´ÂÁ¡ ¹üÀ§: ÇØ´ç¾øÀ½ ¢ÂÆø¹ß¼º:ÀÚ·á¾øÀ½ ¢Â»êȼº: ÀÚ·á¾øÀ½ ¢ÂÁõ±â¾Ð: ÀÚ·á¾øÀ½ ¢ÂºñÁß : ÀÚ·á¾øÀ½ ¢ÂºÐ¹è°è¼ö: ÀÚ·á¾øÀ½ ¢ÂÁõ±â¹Ðµµ: ÀÚ·á¾øÀ½ ¢ÂÁ¡µµ: ÇØ´ç¾øÀ½ ¢ÂºÐÀÚ·®: 241.84 |
| ¢Â BRONOPOL
¢Â¿ë µµ: Á¦Áö Slime controlÁ¦,¶óÅØ½º,ÀüºÐÈ£·á,¼¶À¯À¯Á¦,Cosmetics, °øÁ¤¼öµîÀÇ Á¦Ç° ºÎÆÐ ¹× º¯Áú¹æÁö |
| ¢Â CMDN
¢Â¿ë µµ: Á¦Áö¿ë Slime controlÁ¦,¶óÅØ½º,ÀüºÐÈ£·á,¼¶À¯À¯Á¦,Cosmetics,¸ñÀç, Paint,±Ý¼Ó Àý»èÀ¯,°øÁ¤¼öµîÀÇ Á¦Ç° ºÎÆÐ ¹× º¯Áú¹æÁö |
| ¢Â GDA
¢Â¿ë µµ: Á¦Áö DIP°øÁ¤Áß Enzyme »ý¼º ¾ïÁ¦¿ëÀ¸·Î °ú»êȼö¼Ò¼ö,±Ô»ê¼Ò´Ù µîÀÇ DIP°øÁ¤ ¾àǰ Àý°¨È¿°ú. |
|
¢Â IPBC
¢Â¿ë µµ: µµ·á,¿¡¸ÖÁ¯,¼¶À¯,Àý»èÀ¯,¸ñÀç µîÀÇ Fungicide. ¢ÂÀå Á¡: Blue stain fungi(Aureobasidium pullulans, Sclerophoma pityophila), sapstainers(Diplodia natalensis, Ceratocystis virescens, Ceratocystis pluriamulata), wood rotting fungi(Coniophora puteana, Polyporus versicolor, Poria monticola, Gloeophyllum trabeum, Lenzites trabea) µîÀÇ ´Ù¾çÇÑ °õÆÎÀÌ¿¡ ´ëÇØ ¸Å¿ì ¿ì¼öÇÑ È¿°ú¸¦ ³ªÅ¸³À´Ï´Ù.
|
 |
¢Â OIT
¢Â¿ë µµ: µµ·á,¸ñÀç,Á¢ÂøÁ¦,½Ç¶õÆ®,¶óÅØ½ºµµ·á,°¡Á× µîÀÇ ¿È¹æÁö¿ë. ¢ÂÀå Á¡ ¡á¸ñÀç, ÆäÀÎÆ® µµ¸· µîÀÇ Ç¥¸é¿¡¼ ¿ì¼öÇÑ °õÆÎÀÌ ¹æÁö È¿°ú¸¦ ³ªÅ¸³À´Ï´Ù. ¡á³»¿¼ºÀÌ ¿ì¼öÇÏ¿©, »ç¿ë¹üÀ§°¡ ³Ð½À´Ï´Ù. ¡áÀú³óµµ¿¡¼µµ ¿ì¼öÇÑ È°¼ºÀ» º¸À̸ç, ¾àÈ¿°¡ Àå±â°£ Áö¼ÓµË´Ï´Ù. ¡á»ç¿ë³óµµ¿¡¼ µ¶¼ºÀÌ ¸Å¿ì ÀÛ½À´Ï´Ù. ¡á°ÅǰÀÌ »ý±âÁö ¾ÊÀ¸¸ç, Formaldehyde°¡ ¹ß»ýÇÏÁö ¾Ê½À´Ï´Ù. ¡á´Ù¸¥ ¹æ±ÕÁ¦¿¡ ºñÇØ ¼¼±Õ¿¡ ´ëÇÑ È¿°ú°¡ ¿ì¼öÇÕ´Ï´Ù. |
| ¢Â DBN
¢Â¿ë µµ: µµ·á,¼öó¸®,Á¦Áö¿ë ¹æºÎÁ¦·Î ±âÁ¸ÀÇ ¾î¶² ¾àÁ¦º¸´Ù »ýºÐÇØ´ÉÀÌ ÁÁ¾Æ ÈÄó¸® ºÎÇϰ¡ °ÅÀÇ ¾ø´Â ½ÅÁ¦Ç°ÀÓ. |
 |
¢Â BIT
¢Â¿ë µµ: ¿¡¸ÖÁ¯,PVC,µµ·á,Paint,Plastic¿ë. ¢ÂÀå Á¡ ¡ápH ¾ÈÁ¤¼ºÀÌ ¿ì¼öÇϹǷÎ, ³ÐÀº pH ¹üÀ§¿¡¼ »ç¿ëÇÒ ¼ö ÀÖ½À´Ï´Ù. ¡á³»¿¼ºÀÌ ¿ì¼öÇÏ¿©, »ç¿ë¹üÀ§°¡ ³Ð½À´Ï´Ù. ¡áÀú³óµµ¿¡¼µµ ¿ì¼öÇÑ È°¼ºÀ» º¸À̸ç, ¾àÈ¿°¡ Àå±â°£ Áö¼ÓµË´Ï´Ù. ¡á»ýºÐÇØ¼ºÀÌ ¿ì¼öÇÏ¿© ȯ°æ¹®Á¦¸¦ ÀÏÀ¸Å°Áö ¾Ê½À´Ï´Ù. ¡á°ÅǰÀÌ »ý±âÁö ¾ÊÀ¸¸ç, Formaldehyde°¡ ¹ß»ýÇÏÁö ¾Ê½À´Ï´Ù. |
| ¢Â HAE
¢Â¿ë µµ: ±¤¹üÀ§ÇÑ Áö¼Ó·ÂÀ» °®´Â ¹æºÎÁ¦·Î Áß¼º ¹× ¾ËÄ«¸®¼º Á¦Ç°¿¡ È¿°ú°¡ ÀÖ°í ¶óÅØ½º,ÆäÀÎÆ®,¿¡¸ÖÁ¯¼öÁö,Á¢ÂøÁ¦,¾È·áºÐ»êÁ¦,½Ã¸àÆ®°áÇÕ,Àý»èÀ¯ µî¿¡ À¯¿ëÇÑÁ¦Ç°. |
| ¢Â HMIT
¢Â¿ë µµ: Á¦Áö¿ë Slime controlÁ¦,¶óÅØ½º,ÀüºÐÈ£·á,¼¶À¯À¯Á¦,Cosmetics,¸ñÀç, Paint,ÈÀåǰµî À§»ýǰ¿ë,±Ý¼Ó Àý»èÀ¯,°øÁ¤¼öµîÀÇ Á¦Ç° ºÎÆÐ ¹× º¯Áú¹æÁö |
| ¢Â ¹«´Ì¸ñ¹æºÎÁ¦
¢Â¿ë µµ: |
|